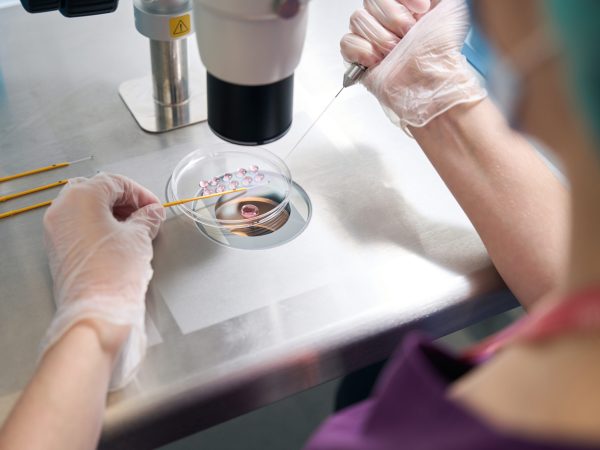

Our pioneering doctors and advanced technology provide exceptional care, helping thousands of families fulfill their dream of parenthood. With a higher success rate than many major facilities and more affordable pricing—partially subsidized by RAMQ—we ensure that the journey is as smooth as possible. We welcome everyone and offer support in multiple languages, because your dream deserves to come true.
Enjoying each step of the process is as important as the process itself !
Led by Prof. Tan, who trained with and partnered Nobel Laureate Prof. Robert Edwards. He is the first IVF doctor with an endowed chair at...

Baseline Ultrasound
Sonohysterogram (Fallopian Tubes, Uterine Cavity Assessment & HyFoCy)
Mock Transfer (Uterine Cavity Length Assessment)
Vitality Scan

IVF (In Vitro Fertilization)
ICSI (Intracytoplasmic Sperm Injection)
Egg Donation IVF Cycle
Frozen Embryo Transfer Cycle (FERC)
Frozen Egg IVF Cycle (FORC) — includes one transfer and one year of storage
PGT-A (Chromosome Analysis)
PGT-M (Genetic Condition Screening)

DNA Fragmentation

Assisted Hatching (AH)
Zymot
Embryo Glue
Embryoscope (Time Lapse Monitoring)
TESA
Baseline Ultrasound
Sonohysterogram (Fallopian Tubes, Uterine Cavity Assessment & HyFoCy)
Mock Transfer (Uterine Cavity Length Assessment)
Vitality Scan
IVF (In Vitro Fertilization)
ICSI (Intracytoplasmic Sperm Injection)
Egg Donation IVF Cycle
Frozen Embryo Transfer Cycle (FERC)
Frozen Egg IVF Cycle (FORC) — includes one transfer and one year of storage
PGT-A (Chromosome Analysis)
PGT-M (Genetic Condition Screening)
DNA Fragmentation
Assisted Hatching (AH)
Zymot
Embryo Glue
Embryoscope (Time Lapse Monitoring)
TESA

Baseline Ultrasound
Sonohysterogram (Fallopian Tubes, Uterine Cavity Assessment & HyFoCy)
Mock Transfer (Uterine Cavity Length Assessment)
Vitality Scan

IVF (In Vitro Fertilization)
ICSI (Intracytoplasmic Sperm Injection)
Egg Donation IVF Cycle
Frozen Embryo Transfer Cycle (FERC)
Frozen Egg IVF Cycle (FORC) — includes one transfer and one year of storage
PGT-A (Chromosome Analysis)
PGT-M (Genetic Condition Screening)

DNA Fragmentation
Assisted Hatching (AH)
Zymot
Embryo Glue
Embryoscope (Time Lapse Monitoring)
TESA
Baseline Ultrasound
Sonohysterogram (Fallopian Tubes, Uterine Cavity Assessment & HyFoCy)
Mock Transfer (Uterine Cavity Length Assessment)
Vitality Scan
IVF (In Vitro Fertilization)
ICSI (Intracytoplasmic Sperm Injection)
Egg Donation IVF Cycle
Frozen Embryo Transfer Cycle (FERC)
Frozen Egg IVF Cycle (FORC) — includes one transfer and one year of storage
PGT-A (Chromosome Analysis)
PGT-M (Genetic Condition Screening)
DNA Fragmentation
Assisted Hatching (AH)
Zymot
Embryo Glue
Embryoscope (Time Lapse Monitoring)
TESA

Discover world-class fertility care in our warm, modern clinics located in Montreal and Ottawa.
Both centers are fully equipped to provide comprehensive, compassionate treatment in a calming and supportive environment.
And while you’re on your journey, enjoy all that Montreal has to offer — from world-renowned cuisine and culture, to vibrant neighborhoods and unforgettable experiences. Our Montreal clinic is just minutes away from shopping, hotels, fine dining, and wellness services — ensuring comfort beyond the clinic walls.
At OriginElle, we understand that time matters. That’s why we offer first consultations in less than 2 weeks.

Everyone deserves a chance to grow their family — no matter their background, orientation, or identity. We proudly welcome LGBTQ+ individuals and couples, and provide care in English, French, Mandarin, Cantonese, Arabic, Hebrew, Hindi, and Spanish to make sure you feel seen, heard, and supported at every step.
From first consultations to life-changing results, our patients share their heartfelt stories. Discover how compassionate care and real expertise made all the difference.

We had a very positive experience at OriginElle clinic and all the staff was very nice and attentive. We were well taken care of by doctor Dahan and Darina Groucha and they always did follow-ups to make sure everything was okay. We are very grateful to the entire team for their help and constant care and are very happy to have met them. Thank you again for everything, doctor Dahan!
Gabriella C Founder & CEO of XpeedStudio
Me and my wife have had the best experience at the clinic over the past 7-8 months of our visit. Everyone working there is really nice, warm and professional. This is definitely one of the best clinics in Montreal and we have never had a bad time there.
Sanchit Ahirrao
My wife and I would like to thank Dr.Tan and his entire team for always being passionate and professional on our journey.When other clinics turned us away and put us on very long waiting lists just to get a consultation, Originelle was open and friendly to listen and help us immediately.Some reviews mention long waits but it is understandable. They are truly trying to help as many people as they can and take on more challenging patient cases that other clinics would not even consider taking.
Tim V.
Words cannot describe the gratitude towards Dr. Tan, the nurses and the staff at Originelle.That type of expertise, academic and professional, is hard to impossible to find in Quebec.As a woman over the age of 40, it was important for me to find a clinic that was ready to go above and beyond the basic protocole available in most other clinics - all the minute details are taken in consideration in order to aim for success. It is not surprising that they have the highest R & D activities.All that being said, as it is a difficult road for all, I strongly recommend going through the experience with a therapist. It will make a great difference.Thank you again, Dr. Tan, as we now have a healthy baby boy! 🙂For all hesitating to start their fertility journey, do not wait longer than necessary and go with what I believe to be the best.Courage!
Jennifer D.
Got our first appointment in less then 3 months.. Dr Chan did miracles with my husband. Dr Tan and Deena did miracles with my follicles (I was a poor responder and I’ve been able to grow more than 20 follicles during the stimulation). Olga and Eli are also a really good members of the team and they respond really quick to our questions. Highly recommend this clinic
Anne-Sophie De La Durantaye
We have had a wonderful experience at this clinic. In fact, we were previously at a different clinic and decided to switch because we were not receiving the support we needed. The entire Originelle staff from the receptionists to the andrologists to the clinical director are extremely accessible, friendly, and helpful. You will not be waiting long to have your calls returned or questions answered. We have felt comfortable and well cared for from the beginning of our treatment there, and this is really really important when going through the emotionally and physically taxing journey that is infertility. Thank you, Originelle!!
Alexa
At OriginElle, we believe you deserve:

Led by Prof. Tan, who trained with and partnered Nobel Laureate Prof. Robert Edwards. He is the first IVF doctor with an endowed chair at a top 10 global university, a dual Gold Medalist (Howard Eddey & MRCOG), former McGill OBGYN Chair (1994–2010), visiting professor at Oxford, UCL, Harvard, and Beijing, and TSRM Lifetime Achievement honoree
I had the pleasure of speaking with Selma from OriginElle Clinic, and I couldn’t be more grateful for her understanding and patience. She truly listened and empathized with my unique situation, providing the support I needed without any pressure. Selma gave me the time and space to make an informed decision at my own pace, which I deeply appreciate. Her compassionate approach made a world of difference. Thank you, Selma, for your kindness and professionalism.
Oshrat David